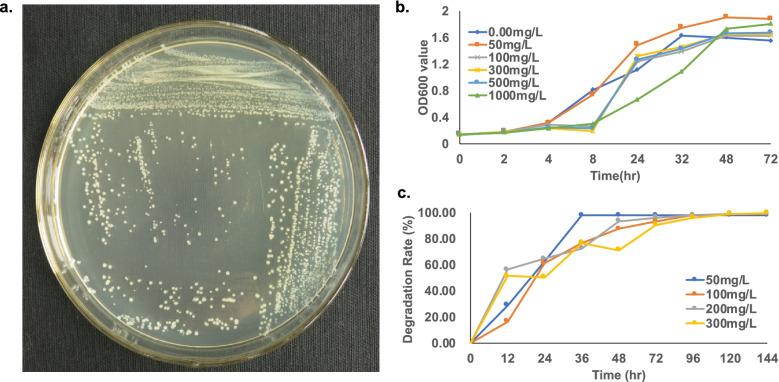

基于 Nanopore MinION 和 Illumina 技术的粪产碱杆菌 PGB1 基因组和耐药组分析。
Genomic and resistome analysis of Alcaligenes faecalis strain PGB1 by Nanopore MinION and Illumina Technologies.
机构信息
Geneis (Beijing) Co., Ltd, Beijing, 100102, China.
Qingdao Geneis Institute of Big Data Mining and Precision Medicine, Qingdao, People's Republic of China.
出版信息
BMC Genomics. 2022 Apr 20;23(Suppl 1):316. doi: 10.1186/s12864-022-08507-7.
BACKGROUND
Drug-resistant bacteria are important carriers of antibiotic-resistant genes (ARGs). This fact is crucial for the development of precise clinical drug treatment strategies. Long-read sequencing platforms such as the Oxford Nanopore sequencer can improve genome assembly efficiency particularly when they are combined with short-read sequencing data.
RESULTS
Alcaligenes faecalis PGB1 was isolated and identified with resistance to penicillin and three other antibiotics. After being sequenced by Nanopore MinION and Illumina sequencer, its entire genome was hybrid-assembled. One chromosome and one plasmid was assembled and annotated with 4,433 genes (including 91 RNA genes). Function annotation and comparison between strains were performed. A phylogenetic analysis revealed that it was closest to A. faecalis ZD02. Resistome related sequences was explored, including ARGs, Insert sequence, phage. Two plasmid aminoglycoside genes were determined to be acquired ARGs. The main ARG category was antibiotic efflux resistance and β-lactamase (EC 3.5.2.6) of PGB1 was assigned to Class A, Subclass A1b, and Cluster LSBL3.
CONCLUSIONS
The present study identified the newly isolated bacterium A. faecalis PGB1 and systematically annotated its genome sequence and ARGs.
背景
耐药菌是抗生素耐药基因(ARGs)的重要载体。这一事实对于开发精确的临床药物治疗策略至关重要。长读测序平台,如牛津纳米孔测序仪,可提高基因组组装效率,尤其是与短读测序数据结合使用时。
结果
从一株对青霉素和其他三种抗生素均具有耐药性的粪产碱杆菌 PGB1 中分离并鉴定出来。使用 Nanopore MinION 和 Illumina 测序仪对其进行测序后,进行了混合组装。共组装出 1 条染色体和 1 个质粒,注释了 4433 个基因(包括 91 个 RNA 基因)。对菌株进行了功能注释和比较,并进行了系统发育分析,结果表明它与粪产碱杆菌 ZD02 最为接近。还对耐药组相关序列进行了探索,包括 ARGs、插入序列和噬菌体。确定了两个质粒上的氨基糖苷类基因是获得性 ARGs。主要的 ARG 类别是抗生素外排耐药和 PGB1 的β-内酰胺酶(EC 3.5.2.6)被归类为 A 类、A1b 亚类和 LSBL3 簇。
结论
本研究鉴定了新分离的粪产碱杆菌 PGB1,并系统注释了其基因组序列和 ARGs。